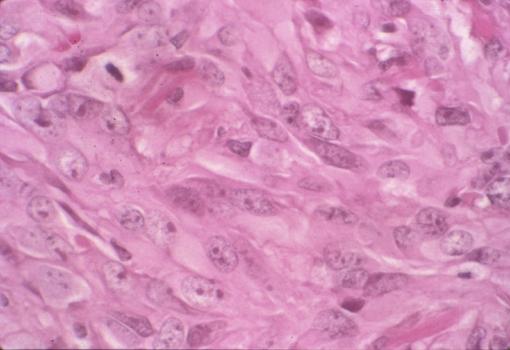

本サイトは、厚生労働省がん研究助成金総合研究事業および、厚生労働省第3次対がん総合戦略研究事業にて構築され、2014年3月にその事業を終了しております。現在サイトに掲載されている内容は当時の登録状況のまま公開しているため、必ずしも最新の医療に沿う内容ではない場合がございます。ご注意ください。
ご不明点がありましたら九州がんセンターまでお問い合わせください。
 |



|
背景色の変更 [ 画像ID:2431 ]3年3ヶ月間に約2.5倍増大した胃の平滑筋肉腫(66才,男)の病理組織像(ミクロ) 腫瘍の強拡大像です。腫瘍細胞は卵円形から紡錐形を呈しており、核はやや腫大しています。また細胞密度が高く、核分裂像も散見されます。平滑筋肉腫に合致する所見です。 ■詳細データ
| ||||||||||||||||||||||||||||
 |
▲先頭へ |